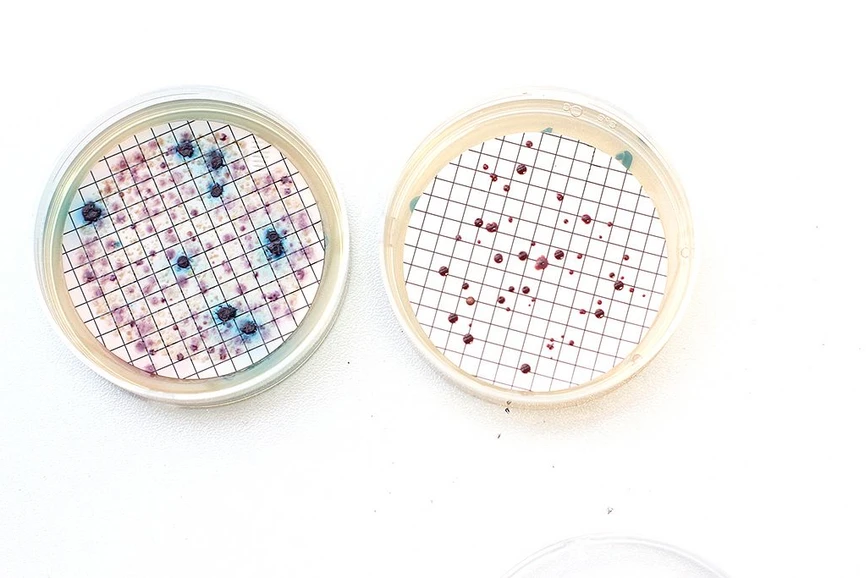
CXI TUL: Patogeny ve vodě odhalíme za několik hodin.

Patogeny ve vodě odhalíme za několik hodin

CXI TUL: Patogeny ve vodě odhalíme za několik hodin
Na výsledky rozboru vody se dosud čekalo i několik dní, s novou metodou založenou na qPCR analýze máme výsledky do pěti hodin. Právě rychlost může být pak naprosto zásadní v přijetí účinných opatření pro ochranu zdraví.
Novinka totiž detekuje a identifikuje DNA patogenních mikroorganismů, v laboratoři se tedy nemusí bakterie kultivovat v živných roztocích a čekat i několik dní až jejich kolonie v Petriho miskách narostou. Metoda je dostupná v Analytické laboratoři CXI TUL.
„Výsledky jsme schopni získat už během několika hodin od přivezení vzorku. To umožňuje provozovatelům vodovodních systémů reagovat prakticky okamžitě – například upravit provoz, provést dezinfekci nebo omezit používání vody ještě předtím, než se problém rozšíří,“ vysvětluje Magda Nechanická z Oddělení technologie životního prostředí Ústavu pro nanomateriály, pokročilé technologie a inovace TUL (CXI), která novou metodu vyvinula a ověřila.
Rychlost detekce je pak klíčová zejména u patogenů, které mohou představovat významné zdravotní riziko, jako jsou například escherichia coli nebo legionella pneumophila.
 CXI TUL: Patogeny ve vodě odhalíme za několik hodin.
CXI TUL: Patogeny ve vodě odhalíme za několik hodin.
Jediná v kraji i v republice
Rychlý molekulárně-genetický rozbor založený na qPCR analýze nyní nabízejí široké veřejnosti v Analytické laboratoři CXI TUL jako jediné pracoviště v Libereckém kraji. „Zájemci si u nás mohou nechat provést jak běžné laboratorní analýzy vody, tak i moderní qPCR analýzu zaměřenou na rychlou detekci patogenů ve vodě nebo v biofilmu,“ říká Lenka Lacinová z Analytické laboratoře CXI TUL. Laboratoř mimo zmíněné poskytuje i akreditované odběry a rozbory pitných, teplých, koupacích vod, kontroly sterilizátorů a autoklávů.
CXI TUL je zároveň prvním pracovištěm v České republice, které tuto metodiku vyvinulo, ověřilo a úspěšně dovedlo až do fáze oficiální akreditace a je to nyní jediná laboratoř v České republice, která je schopná analyzovat celou sadu mikrobiologických organismů z pitných, rekreačních i teplých vod.
Budoucnosti v monitoringu vody
Další významnou výhodou molekulárně-genetických metod je, že se neomezují pouze na mikroorganismy, které lze kultivovat v laboratoři. qPCR analýza dokáže zachytit i patogeny přítomné v biofilmech nebo ve formách, které běžné metody přehlédnou, a poskytuje tak realističtější obraz o skutečném stavu vodních systémů.
Molekulárně-genetické metody tak mají potenciál stát se důležitou součástí rutinního monitoringu vody. Jejich využití přináší rychlejší identifikaci problémů, účinnější ochranu veřejného zdraví a celkově vyšší bezpečnost vodních zdrojů.
Tato technologie tak představuje významný krok směrem k modernizaci vodohospodářské praxe v České republice.
Vývoj metodiky na CXI probíhal díky podpoře z programu TA ČR SIGMA a od počátku se zaměřil nejen na vědecký výzkum, ale především na praktické využití. Cílem bylo dovést technologii až do fáze oficiální akreditace, která je nutnou podmínkou pro její použití v laboratorní praxi. A to se podařilo. Technologie z TUL je nyní k dispozici vodohospodářům, hygienickým stanicím i široké veřejnosti.
O metodu je zájem nejenom v odborné komunitě, ale také mimo ni.
- Reportáž na TV Nova sledujte od stopáže 25:12
- ČT televize
- Prima CNN
CXI TUL: Patogeny ve vodě odhalíme za několik hodin.
CXI TUL: Patogeny ve vodě odhalíme za několik hodin.




